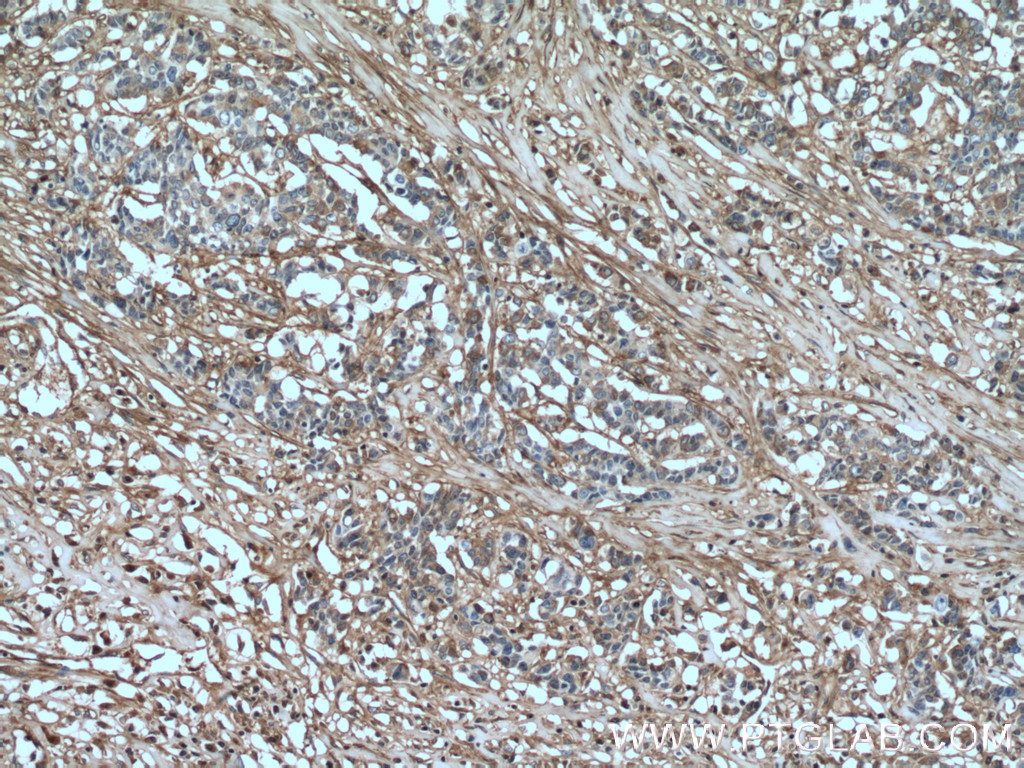
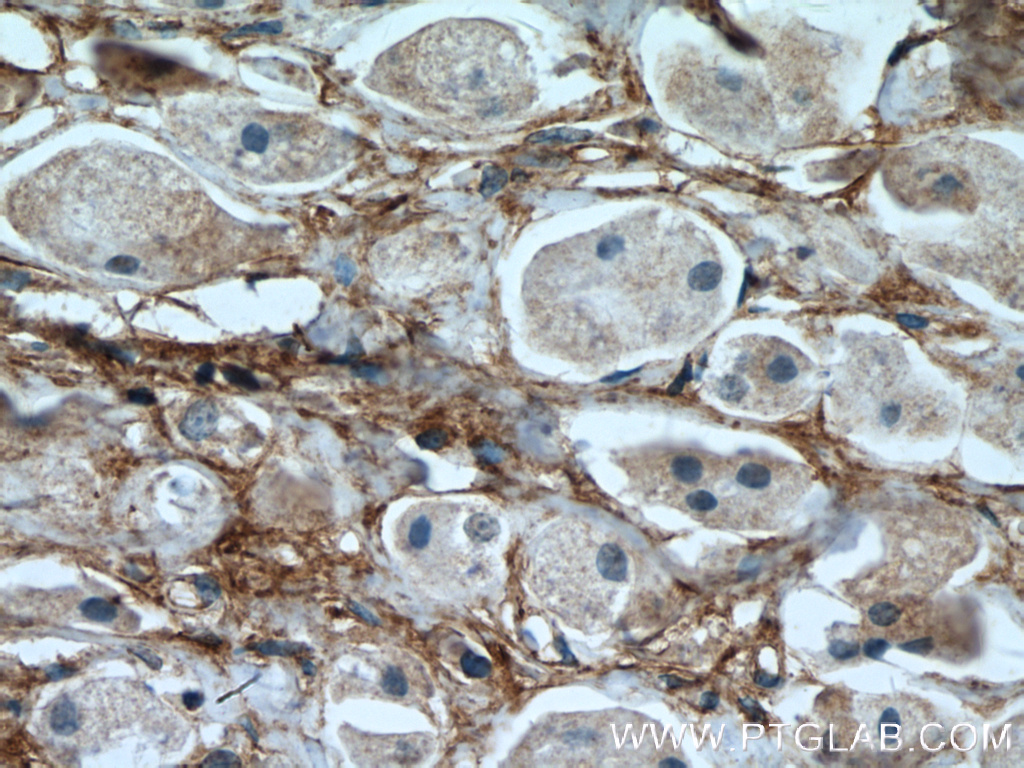

验证数据展示
产品信息
66042-1-PBS targets Fibronectin in WB, IHC, IF/ICC, IF-P, IP, ELISA applications and shows reactivity with human, mouse, rat samples.
| 经测试应用 | WB, IHC, IF/ICC, IF-P, IP, ELISA Application Description |
| 经测试反应性 | human, mouse, rat |
| 免疫原 |
CatNo: Ag8016 Product name: Recombinant human FN1 protein Source: e coli.-derived, PET28a Tag: 6*His Domain: 2177-2386 aa of BC005858 Sequence: DQQRHKVREEVVTVGNSVNEGLNQPTDDSCFDPYTVSHYAVGDEWERMSESGFKLLCQCLGFGSGHFRCDSSRWCHDNGVNYKIGEKWDRQGENGQMMSCTCLGNGKGEFKCDPHEATCYDDGKTYHVGEQWQKEYLGAICSCTCFGGQRGWRCDNCRRPGGEPSPEGTTGQSYNQYSQRYHQRTNTNVNCPIECFMPLDVQADREDSRE 种属同源性预测 |
| 宿主/亚型 | Mouse / IgG1 |
| 抗体类别 | Monoclonal |
| 产品类型 | Antibody |
| 全称 | fibronectin 1 |
| 别名 | FN1, 1G10F9, Anastellin, CIG, Cold insoluble globulin |
| 计算分子量 | 2386 aa, 263 kDa |
| 观测分子量 | 263 kDa |
| GenBank蛋白编号 | BC005858 |
| 基因名称 | Fibronectin |
| Gene ID (NCBI) | 2335 |
| RRID | AB_11182385 |
| 偶联类型 | Unconjugated |
| 形式 | Liquid |
| 纯化方式 | Protein G purification |
| UNIPROT ID | P02751 |
| 储存缓冲液 | PBS only, pH 7.3. |
| 储存条件 | Store at -80°C. The product is shipped with ice packs. Upon receipt, store it immediately at -80°C |
背景介绍
Fibronectin 1 (FN1) is a high molecular weight glycoprotein which exists in both a soluble form in plasma (plasma FN1) and other body fluids and an insoluble form in the extracellular matrix (cellular FN1). Plasma FN1 (dimeric form) is secreted by hepatocytes. Cellular FN (dimeric or cross-linked multimeric forms), made by fibroblasts, epithelial and other cell types, is deposited as fibrils in the extracellular matrix. FN1 binds to cell surfaces through integrins and to various compounds including collagen, fibrin and heparin. It is involved in cell adhesion and migration processes including embryogenesis, wound healing, hemostasis, host defense, and metastasis. (PMID: 7276612; 12244123; 12847088)